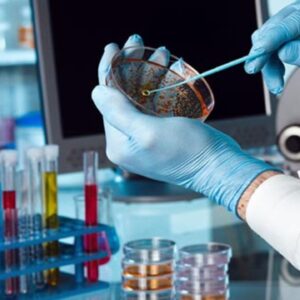
Curso Introdução à Biotecnologia

Conteúdo Programática:
- Microscopia Eletrônica de Varredura (MEV)
- Microscopia Eletrônica de Transmissão (TEM)
- Microscopia Eletrônica de Transmissão de varredura (STEM )
- Microscopia de força atômica (AFM)
- A microscopia óptica avançada (MOA)
- Microbiologia

Avaliações
Não há avaliações ainda.